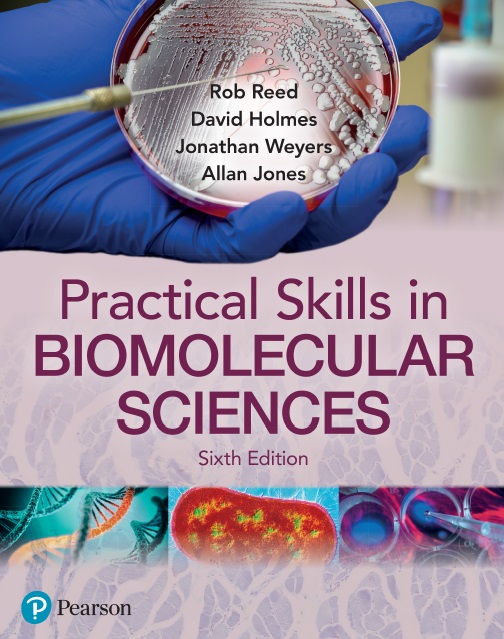

Practical Skills in Biomolecular Sciences 6th Edition
Rob Reed, Jonathan Weyers, David Holmes, Allan Jones, 9781292397085, 978-1292397085, 978-1-292-39708-5, 978-1-292-39709-2, 978-1292397092, 9781292397092, 978-1-292-39710-8, 978-1292397108, 9781292397108, 129239708X
An essential companion for students across a range of disciplines, including biochemistry, biomedical sciences, microbiology and molecular biology throughout your entire degree programme, this sixth edition of Practical Skills in Biomolecular Sciences, has been updated and expanded to provide you with a complete and easy-to-read guide. It’s an all-in-one solution for the key practical skills needed for all cellular and molecular life sciences, including: comprehensive coverage of study and examination skills; fundamental laboratory methods; investigative and analytical techniques and analysis and presentation of data.
This new edition comes with increased coverage on laboratory skills, new chapters on working with bacteria, eukaryotic microbes and viruses, and on assaying biomolecules, as well as new sections on online learning in a post-COVID world. In addition, 250 new and updated illustrations, tables, and tips – including 25 new ‘how to’ boxes – have been added, along with numerous end-of-chapter study exercises (with answers provided on the companion website) to support self-evaluation.